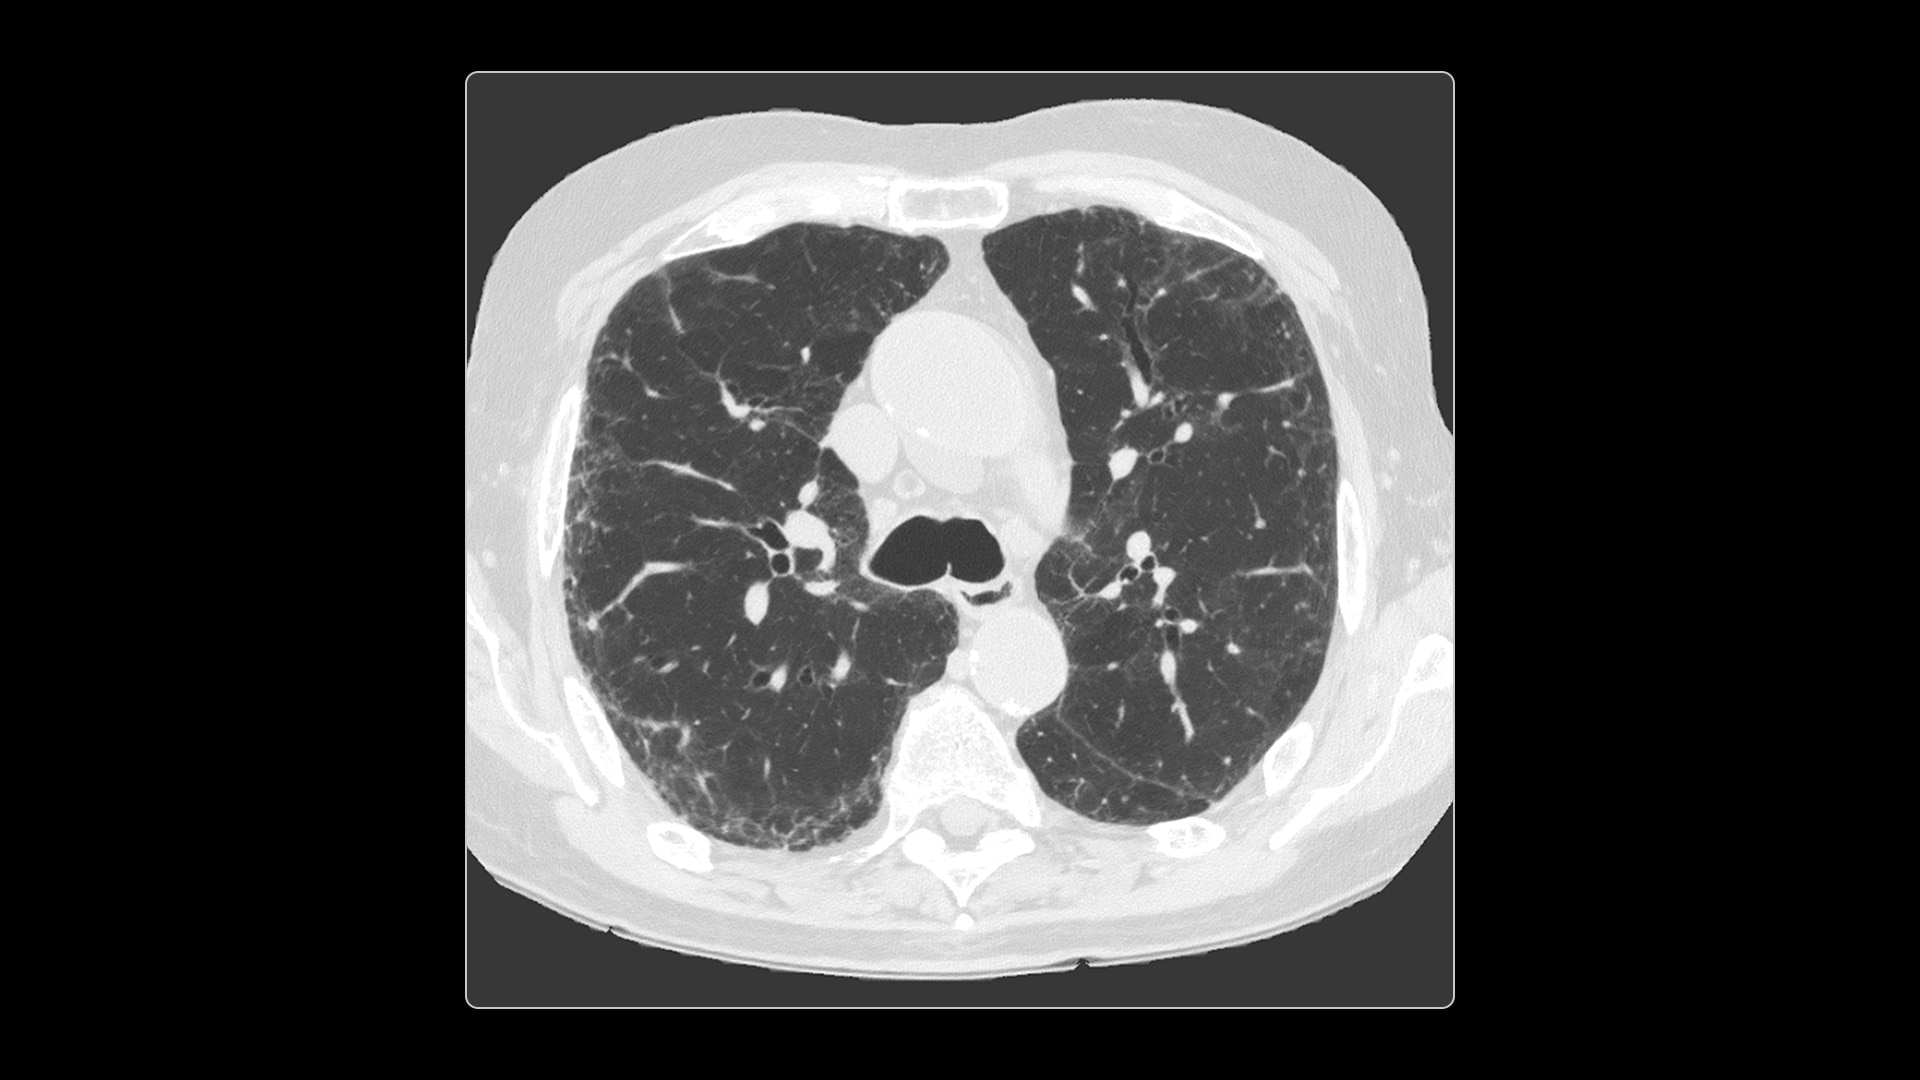
Product Media Carousel Image

On-demand spectral imaging enabled by 8-energy bins
Our advanced spectral imaging capabilities are intended to allow you to experience the difference between seeing and knowing so you can confidently detect, characterize and monitor disease.
Photonova Spectra is also designed to enhance material separation for tissue characterization and disease quantification, bringing potentially greater diagnostic confidence in every acquisition across care areas.
A full range of spectral imaging series is generated natively on console and available for transfer to PACS. The full-fidelity spectral data acquisition is intended to provide native DICOM images and material maps to support clinical diagnosis, with improvements of up to 4x enhanced energy discretization1, 2x higher material map spatial resolution2, and 2x improved iodine detectability3.
1. Than compared to dual energy CT.
2. Compared to Revolution Apex with Gemstone Spectral Imaging (GSI), based on 10% MTF measurements in iodine (water) phantom images using the highest available resolution kernel on Photonova Spectra and on Revolution Apex with GSI at matched dose. 10 mg/mL iodine concentration was used for the measurement.
3. Iodine detectability defined as the lowest iodine concentration the system can detect. Photonova Spectra delivers a 2x and greater improvement in iodine detectability, compared to Revolution Apex. It has the ability to detect iodine concentrations down to 0.2 mg/mL at a radiation dose of 8 mGy, using Gammex Multi‑Energy CT Phantom with water and a 0.2 mg/mL iodine insert. Dose based on a 32 cm dosimetry phantom.